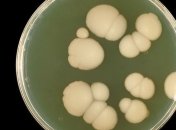
Ученые обнаружили смертельный грибок

Новости по теме Микробы
-

Большинство людей не знают: этот предмет в ванной нужно стирать почаще.
-

В сети не верят, что на гаджете может жить столько организмов
-

Цветной снег ускоряет глобальное потепление на Земле
-

Лед из Тибета привезли в США еще в 2015 году.
-

Евгений Комаровский назвал места, которые больше всего кишат вредными микробами.
-

При хранении яиц попавшие в них микроорганизмы могут размножаться и вызывать их порчу.
-

Исследователи из Японии и США в ходе исследования морского дна обнаружили бактерий, живших сто миллионов лет назад. После "откармливания" в лабораторных условиях, их удалось вернуть к жизни.
-

Одним из способов обезопасить себя может стать частое мытье рук.
-

Исследования показывают – в обычной городской квартире грязи обычно больше чем на улице за окном.
-

Ученые создали модель, прогнозирующую процесс адаптации микробов к потеплению океанов.
-

Ученые не нашли общих приспособлений к взаимодействию с теми или иными бактериями у млекопитающих.
-

Многие исследования кишечного микробиома и его воздействия на макроорганизм хозяина сосредотачивались на отдельных видах микроорганизмов.
-

Впервые за 14 лет ученые погрузились к месту крушения лайнера и выяснили, что примерно к 2030 году он может полностью исчезнуть.
-

Поэтому мышьяк ядовит практически для всех организмов - за отдельными примечательными исключениями.
-

Некоторые микробы, попадающие в наш организм, могут "убить" своих друзей - полезные бактерии, что негативно скажется на общем самочувствии.
-
Специалисты утверждают: мир поглощает опаснейшая разновидность грибка, возникновение которого связано с постоянным использованием антимикробных средств.







